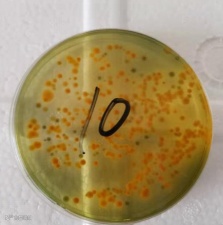
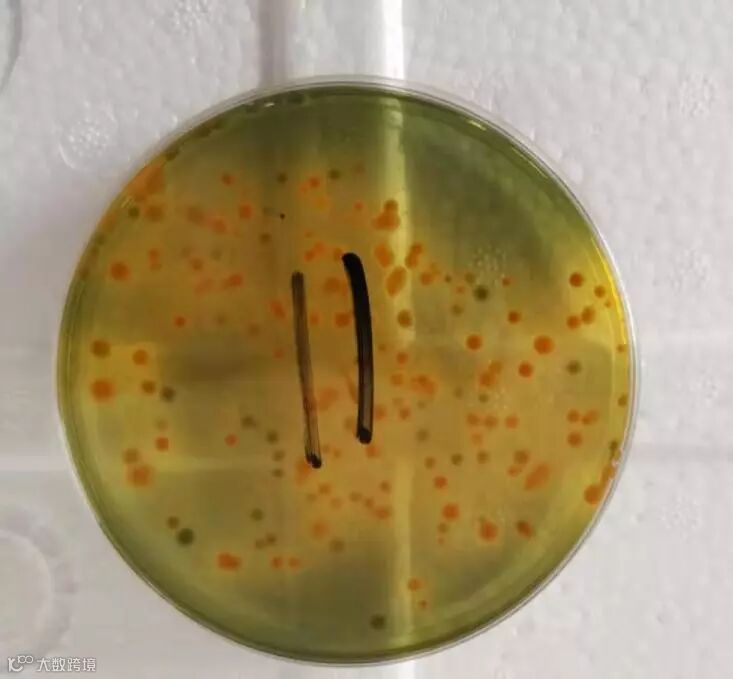

点击蓝字 关注我们
在水产动物中,每年大部分时间会发生弧菌病,尤其在夏末高温期爆发最为严重和频繁。最近很多塘口都爆发了弧菌病,经检测水样藻类缺乏,水体氨氮、亚硝酸盐含量也较高,TCBS涂板大量霍乱弧菌生长。很多养殖户一看有弧菌,就开始消毒杀菌,但是过几天又会反弹,而且越杀越严重,是怎么回事呢?其实消毒杀菌只是治标不治本,我们必须要从根源上去解决问题。

什么是弧菌
1
弧菌是一种革兰氏阴性菌,菌体短小、弯曲、弧状,尾部带有鞭毛。广泛分布于各种海水水体及动物体内,种类繁多。而能引起水产养殖动物致病的主要有霍乱弧菌、副溶血弧菌、创伤弧菌等,是海水养殖鱼、虾、贝类等的主要流行病原体。
弧菌无处不在,水体中都含有一定数量的弧菌。因此,想要彻底灭杀弧菌是不现实的,只要对弧菌具有一定的了解,通过控制弧菌生长繁殖,使弧菌数量达不到致病浓度,就能够轻松应对弧菌病了。弧菌是一类非常典型的条件致病菌,只有满足一定的条件,才能感染养殖动物。

弧菌如何产生
2
弧菌病的产生是一个综合性的过程,是水质、底质和养殖动物免疫力相互作用的结果。弧菌的突然爆发,一定是水质、底质的恶化导致的,如水体中的残饵、粪便及死藻沉入池塘底部,弧菌附着在这些有机质上生长,再加上池塘长期未进行底改,底部积累大量有机质,底部有机质的分解耗氧产热,为弧菌的生长繁殖创造了一个适宜的高温、营养丰富的厌氧场所。养殖动物长期处于这种恶劣的环境中,导致应激频繁,自身免疫力下降,就容易受到弧菌的入侵。特别是养殖动物体表有寄生虫寄生时,更容易诱发继发性弧菌感染。
因此,如果只是一味的消毒杀菌,并不能根本性的解决问题,而且盲目的消毒杀菌还可能会加剧水体环境的恶化,导致弧菌反复爆发。
防治方法
3
如何从根本上解决弧菌病呢?必须要从水体环境、病原菌和养殖动物本身进行综合调控。
一、调整好池塘环境,不改善环境,弧菌病很难治愈。保持好优良的环境,才能杜绝弧菌的大量繁殖。定期使用强氧化性底改产品“超强底净”,以快速氧化池塘底部的有机质,改善发黑、发臭的底质,并泼洒微生态制剂如光合细菌、芽孢杆菌、EM菌、乳酸菌等分解池塘中不断产生的残饵、粪便及死藻等有机质(建议使用“菌益多”,成本低,一袋扩培后可使用80-100亩),减少弧菌懒以生存的附着场所和营养供给,可有效减缓弧菌的滋生速度。


二、水体消毒,切断弧菌传播途径。定期或养殖对象出现弧菌病症状(如对虾肝胰腺萎缩发红,小龙虾尾部出现水泡等)时,使用“卫泰”对水体进行消毒,该产品为50%过硫酸氢钾复合盐,对控制弧菌有显著的效果,而且在消毒杀菌的过程中还可以释放氧气,提高池塘溶解氧,改善池塘环境;间隔24小时后,再全池泼洒“虾蟹抗菌肽”,能有效控制养殖动物体内外弧菌的滋生,以防弧菌的复发,使水体内弧菌的数量长时间保持在一个较低的水平。

(1)浓度高、用量少、高效迅速,作用更持久。
(2)内服,代替抗生素,清除养殖对象体内弧菌。
(3)外泼,改善水体环境,代替化学消毒剂压制水体弧菌。
三、增强体质,提高养殖动物免疫力,降低感染弧菌几率。使用“虾蟹免疫多维”或者“免疫低聚糖”拌料投喂,免疫力强的往往不容易感染发病;若水体弧菌超标,养殖对象有感染时,内服“虾蟹抗菌肽”和“虾蟹免疫多维”,清除体内弧菌。


总结
4
日常管理中,要做到勤改底、多调水。调理好水质底质环境、提高养殖动物免疫力和定期消毒,基本上就能解决弧菌病的爆发。弧菌大多数为厌氧菌,保持池塘底部容氧,维持好一个清洁的状态,不给弧菌生长繁殖创造条件,并且有利于水质稳定,防止底质恶化,为其他有益菌创造生长繁殖条件,使有益菌处于优势地位,反过来抑制弧菌的生长。



北京中泓鑫海生物技术有限公司


